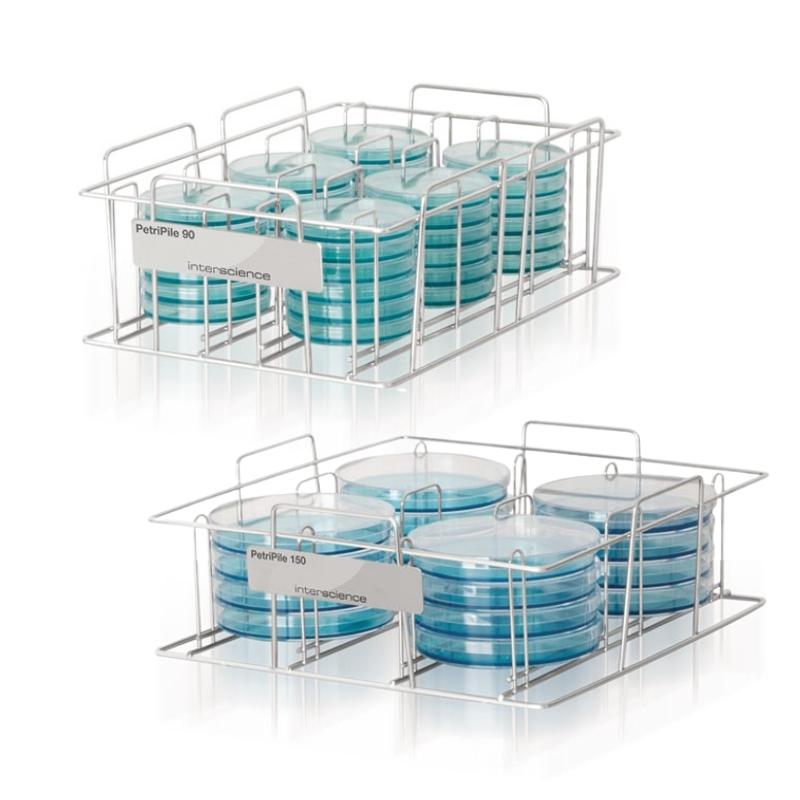

- tel: +381 11 30 16 492
- email: office@vicor.rs
- SERVIS
Stalci za kese za stomaher i petri šolje
Navedena cena je sa uračunatim PDV-om i nema skrivenih troškova.
Dodaci za rad u najboljim uslovima
INTERSCIENCE već 40 godina razvija i proizvodi inovativnu naučnu opremu za mikrobiološke laboratorije. Uređaji garantuju bezbedne i brze analize u laboratorijama kontrole namirnica, farmaceutskoj industriji, zaštiti životne sredine i medicinskim istraživanjima.
Interscience Vam nudi kompletno rešenje za mikrobiološku kontrolu namirnica.
Od uzorka do rezultata!
Cena na upit.
|
stalak za kese od 80 mL / 100 mL / 400 mL / 2000 ml |
|
stalak za BagFilter Pipet & Roll, dealan za rad sa patogenima |
|
stalak kapaciteta 36 petri šolja |

Komentari
Nema komentara za ovaj proizvod. Morate biti prijavljeni kako bi poslali komentar!
Prijavi se